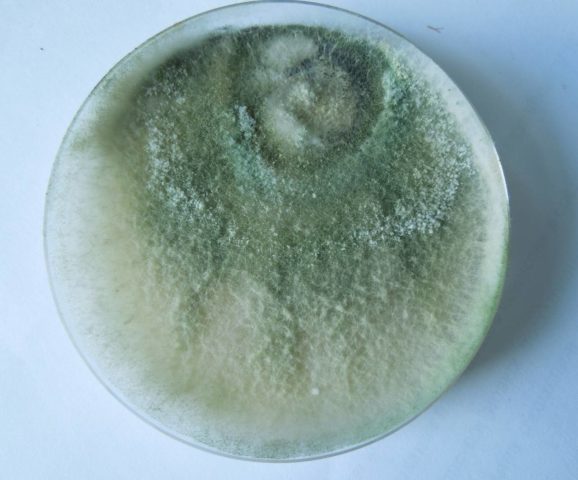

Περιεχόμενο
- 1 Περιγραφή του φαρμάκου Glyocladin
- 2 Οδηγίες για τη χρήση του φαρμάκου Glyocladin
- 3 Πλεονεκτήματα και μειονεκτήματα
- 4 Συμβατότητα με άλλα φάρμακα
- 5 Μέτρα ασφαλείας
- 6 Κανόνες αποθήκευσης
- 7 Τα ανάλογα του Γλυκοκλαδίνου
- 8 συμπέρασμα
- 9 Κριτικές για δισκία Γλυοκλαδίνης
Οδηγίες για τη χρήση της Γλυοκανδίνης για φυτά ισχύουν για όλες τις καλλιέργειες. Το φάρμακο είναι ευρέως γνωστό στους κηπουρούς και είναι ένας από τους καλύτερους βοηθούς στην καταπολέμηση διαφόρων ασθενειών που βρίσκονται στον κήπο. Βοηθά στην αντιμετώπιση ασθενειών φρούτων, μούρων, λαχανικών, καθώς και λουλουδιών και διακοσμητικών θάμνων. Ταυτόχρονα, δεν βλάπτει τα φυτά, το περιβάλλον, δεν βλάπτει τα πουλιά, τα ζώα και τα έντομα, δεν βλάπτει την ανθρώπινη υγεία.

Το εργαλείο εφαρμόζεται πριν από τη σπορά και τη φύτευση δενδρυλλίων
Περιγραφή του φαρμάκου Glyocladin
Η «γλυκολαδίνη» είναι ένα μικροβιολογικό φάρμακο που καταστέλλει την ανάπτυξη μυκητιακών και βακτηριακών ασθενειών στις φυτικές καλλιέργειες. Ανήκει στην κατηγορία μυκητοκτόνων και βιολογικών φυτοφαρμάκων. Το "Glyokladin" και η χρήση του σε οικόπεδα κήπων είναι από καιρό δημοφιλής. Εφαρμόζεται σε σπορόφυτα οπωροφόρων δένδρων, μούρων, λουλουδιών και λαχανικών. Το καλοκαίρι οι κάτοικοι το λατρεύουν για την απλή εφαρμογή και την αποδεδειγμένη αποτελεσματικότητά του.
Η σύνθεση του φαρμάκου Glyocladin
Τα δισκία "Glyokladina" έχουν βιολογική φυλή. Το κύριο συστατικό τους είναι η καλλιέργεια μανιταριών Trichoderma harzianum. Υπό ευνοϊκές συνθήκες, το μυκήλιο του αρχίζει να αναπτύσσεται ενεργά και ο μύκητας που σχηματίζει ασκεί ζωτική δραστηριότητα προστατευτικές δράσεις για τα φυτά, χωρίς να εισέρχεται σε συμβίωση με τις ρίζες τους.
Το δραστικό συστατικό του βιοσυμπλέγματος "Γλυοκλαδίνη" είναι ένα μανιτάρι - Trichoderma
Μορφές έκδοσης
Το Glyokladin κατασκευάζεται από έναν Ρώσο κατασκευαστή, την AgroBioTechnology.
Υπάρχουν διάφορες μορφές κυκλοφορίας του:
- Χάπια. Πωλούνται σε πλαστικά κουτιά και κουτιά για λαχανικά και λουλούδια, 1000 και 100 τεμάχια το καθένα.
- Βρέξιμη σκόνη. Μπορεί να βρεθεί σε δοχεία των 60 g.
- Εναιώρημα. Έτοιμο συμπύκνωμα σε δοχεία των 5 λίτρων.
Σκοπός και αρχή λειτουργίας
Ο κύριος σκοπός του εξαιρετικά αποτελεσματικού βιομυκητοκτόνου εδάφους "Γλυκολαδίνη" είναι η απολύμανση του εδάφους από διάφορες μυκητιασικές λοιμώξεις και τα παθογόνα τους. Πρώτα απ 'όλα, η χρήση της ουσίας αποσκοπεί στην προστασία από τη ρίζα και τη σήψη των ριζών των καλλιεργειών λουλουδιών, αγγουριών και τομάτας.
Η "Γλυκοκαντίνη" εισάγεται συχνότερα στο έδαφος στο στάδιο της καλλιέργειας, κατά τη μεταφύτευση φυτών, καθώς και σε κλειστό έδαφος: σε θερμοκήπια, θερμοκήπια, θερμοκήπια.
Η βάση του συγκροτήματος, που ενεργοποιεί τον μηχανισμό δράσης, είναι το ανταγωνιστικό μανιτάρι Trichoderma. Αφού μπει στο έδαφος, αρχίζει να δημιουργεί ένα ισχυρό μυκήλιο, χρησιμοποιώντας το μυκήλιο των παρασίτων. Έτσι, η ανάπτυξη παθογόνων μικροοργανισμών καταστέλλεται και καταστρέφεται. Επιπλέον, ο μύκητας εκκρίνει αντιβιοτικά που εμποδίζουν την ανάπτυξη πολλών ασθενειών.
Η ουσία χρησιμοποιείται όχι μόνο για ιατρικούς σκοπούς, αλλά και για την απολύμανση του μείγματος εδάφους κατά τη συλλογή φυτών και τη φύτευση τους σε μόνιμο μέρος.
Η «γλυκολαδίνη» διασπά την οργανική ύλη, απελευθερώνει άνθρακα, εμπλουτίζει το έδαφος και επίσης επιταχύνει την ανάπτυξη των φυτών, αυξάνει την ανοσία και την αντοχή τους σε πολλές ασθένειες.
Περιοχή εφαρμογής
Το φάρμακο είναι πολύ διάσημο. Χρησιμοποιείται ως προληπτικό μέτρο και για τη θεραπεία μυκητιασικών ασθενειών σε φυτά εσωτερικού και κήπου, οπωροφόρα δέντρα και λουλούδια. Συνήθως χρησιμοποιείται κατά της σήψης των ριζών και των λοιμώξεων στο έδαφος:
- όψιμη όραση
- κρίση;
- εναλλακτική;
- φουσάριο;
- σπονδυλοπάθεια;
- ριζοκτονία.
Τα δισκία λειτούργησαν καλά κατά του ωιδίου, του ωιδίου και του μωβ.
Ποσοστά κατανάλωσης
Στις οδηγίες για το "Glyokladin" γράφεται ότι σε κάθε περίπτωση χρήσης του παράγοντα, συνιστάται να υπολογίζεται μεμονωμένα η κατανάλωση της ουσίας.
Οι κηπουροί πρέπει να ενεργούν σύμφωνα με το σχήμα:
- Για 300 ml εδάφους, πάρτε 1 δισκίο του φαρμάκου.
- Για μια κατσαρόλα με διάμετρο έως 17 cm, χρειάζεστε 3 χάπια και με μέγεθος 20 cm ή περισσότερο - 4.
- Κατά τη φύτευση λαχανικών, συνιστάται η προσθήκη 3-4 δισκίων ανά τρύπα.
- Κατά τη συλλογή και σπορά σπόρων λουλουδιών, αγγουριών και ντοματών, 1 κομμάτι πρέπει να είναι ενσωματωμένο στο έδαφος. "Γλυκοladina" σε βάθος τουλάχιστον 1 cm.
Για να προετοιμάσετε την υγρή μορφή, πρέπει να προσθέσετε περίπου 50 g του προϊόντος σε 500 ml νερού. Το εναιώρημα πρέπει να χυθεί στη δεξαμενή άρδευσης και να καταναλωθεί εντός δύο ωρών.

Τα δισκία πρέπει να θάβονται στο έδαφος, να μην διαλύονται στο νερό.
Οδηγίες για τη χρήση του φαρμάκου Glyocladin
Όταν χρησιμοποιείτε δισκία "Γλυκολαντίνα" τοποθετούνται στο έδαφος σε βάθος ενάμισι εκατοστών, στεγνώνουν, μία φορά τη σεζόν. Ένα κομμάτι είναι αρκετό για 1 φυτό, τρύπα ή 300-800 ml εδάφους.
Όταν χρησιμοποιείτε εναιώρημα ή σκόνη, το προϊόν αραιώνεται σε νερό σύμφωνα με τις οδηγίες στη συσκευασία. Το υγρό παρασκεύασμα εφαρμόζεται συνήθως την άνοιξη και μια εβδομάδα μετά τον ατμό του εδάφους στο θερμοκήπιο. Η θεραπεία μπορεί να γίνει με ψεκασμό ή πότισμα. Μετά τη διαδικασία, η περιοχή σκάβεται έτσι ώστε τα σπόρια των μανιταριών να κατανέμονται ομοιόμορφα στο έδαφος. Η δοσολογία του υγρού "Γλυκολαδίνη" έχει ως εξής: 1-2 κουβάδες διαλύματος εργασίας ανά 100 m εδάφους ή 60-150 ml εναιωρήματος ανά 1 εκτάριο.
Το φάρμακο διατηρεί τη δράση του στο ανώτερο στρώμα εδάφους. Ιδανικές συνθήκες για αυτό: βάθος ενσωμάτωσης έως 8 cm, υγρασία από 60 έως 80%, θερμοκρασία + 20-25 βαθμούς Κελσίου, οξύτητα 4,5-6. Η απόκλιση από τους κανόνες θα οδηγήσει σε επιβράδυνση της ανάπτυξης μυκηλίου μανιταριών και μείωση της επίδρασης.
Πώς να χρησιμοποιήσετε το Glyocladin για τα φυτά
Για να αποκτήσετε υγιή φυτά, τα δισκία "Γλυκοκαντίνη" εισάγονται στο έδαφος στο στάδιο της συλλογής των φυτρώνων σε προσωρινά κουτιά. Πρέπει να βάλετε μισό δισκίο σε ένα πηγάδι. Όταν φυτεύετε φυτά που καλλιεργούνται στο έδαφος, ο υπολογισμός έχει ως εξής: 1 δισκίο ανά 1 φρεάτιο. Οι δράσεις είναι ιδιαίτερα σχετικές με την καλλιέργεια αγγουριών και ντοματών.

Το προϊόν δεν χρησιμοποιείται για ψεκασμό φυτών
Για καλλιέργειες λαχανικών
Από τις οδηγίες για τη χρήση του "Glyocladin" για φυτά και, κρίνοντας από τις κριτικές των κηπουρών, είναι σαφές ότι το αποτέλεσμα της χρήσης μιας βιολογικής ουσίας θα επιτευχθεί μόνο εάν χρησιμοποιείται σωστά:
- Κατά τη σπορά των σπόρων, τα δισκία πρέπει να προστίθενται στο έδαφος, να τα ποτίζετε καλά και να αφήνετε τα δοχεία με το υλικό φύτευσης ζεστό κάτω από το φιλμ.
- Για την πρόληψη ασθενειών, απλώστε μία φορά (1 τεμάχιο - 1 φυτό).
- Για θεραπεία, χρησιμοποιήστε 2 δισκία ανά φυτό.
- Όταν φυτεύετε πατάτες, προσθέστε 2 χάπια ανά κόνδυλο.
Πώς να χρησιμοποιήσετε το Glyocladin για λουλούδια και διακοσμητικούς θάμνους
Τα δισκία "Glyokladina", κρίνοντας από τις οδηγίες χρήσης και κριτικές, έχουν ευεργετική επίδραση στην ανάπτυξη διακοσμητικών θάμνων και λουλουδιών κήπου. Μετά τη χρήση τους, οι μπουμπούκια γίνονται ισχυρότεροι και μεγαλύτεροι, ανθίζουν περισσότερο. Χρησιμοποιούν το φάρμακο σύμφωνα με το ίδιο σχήμα με τα λαχανικά (1 φυτό - 1 τραπέζι). Σε ζεστό καιρό, το προϊόν διατηρεί τα ευεργετικά του αποτελέσματα για 1-2 μήνες.
Για εσωτερικά λουλούδια και φυτά
Το παρασκεύασμα "Γλυκολαδίνη" για φυτά εσωτερικού χώρου χρησιμοποιείται συνήθως για τη μεταμόσχευσή τους. Βάλτε ένα δισκίο σε μικρά δοχεία, τρία χάπια σε δοχεία με διάμετρο μεγαλύτερη από 17 cm, είναι επιθυμητό να τοποθετήσετε 4 σε μεγάλα δοχεία. Πρώτα, τοποθετήστε τη γη στο δοχείο, τοποθετήστε το "Γλυκολαδίνη" στο κέντρο, φυτέψτε ένα λουλούδι και καλύψτε με χώμα.
Εάν τα χάπια δεν βοήθησαν, αυτό σημαίνει ότι η θεραπεία πραγματοποιήθηκε αργά, και για να ξεπεραστεί η ασθένεια, θα απαιτηθούν ισχυρότερα μέσα.
Για καλλιέργειες φρούτων και μούρων
Για οπωροφόρα δέντρα και μεγάλους θάμνους μούρων, το μυκητοκτόνο χρησιμοποιείται σπάνια και βοηθά μόνο στην πρόληψη ασθενειών. Σε περίπτωση μόλυνσης, η δράση της καθίσταται αναποτελεσματική. Είναι προτιμότερο να χρησιμοποιείται η "Γλυκολαδίνη" για μικρά φυτά: φράουλες, φράουλες, κατά προτίμηση σε υγρή μορφή. Είναι απαραίτητο να ψεκάσετε τους θάμνους στη φάση της ανθοφορίας και της ωρίμανσης των μούρων.

Υγρό διάλυμα "Γλυοκλαδίνης" πρέπει να χρησιμοποιείται το αργότερο 4 ώρες μετά την παρασκευή
Πώς να αντιμετωπίσετε τα σμέουρα με γλυκολαδίνη για μωβ σημείο
Παρόλο που οι οδηγίες για τη χρήση του φαρμάκου Γλυοκλαδίνη για τα φυτά δεν λένε τίποτα για τη θεραπεία της μοβ κηλίδας (μυκητιασική νόσος), οι κηπουροί συμβουλεύουν να το χρησιμοποιήσουν για αυτήν την ασθένεια στα σμέουρα. Η πρώτη θεραπεία πρέπει να γίνεται την άνοιξη, πριν ανοίξουν τα μπουμπούκια. Το δεύτερο (ψεκασμός) - τη στιγμή της ανθοφορίας.
Πώς χρησιμοποιούνται τα δισκία Glyocladin για εμβολιασμό
Το φάρμακο σε μορφή δισκίου μπορεί να χρησιμοποιηθεί για μοσχεύματα ρίζας, ριζοβολία βατόμουρων, σμέουρων και ροδαλών ισχίων (1 μοσχεύματα - 1 δισκίο).
Για να ενισχύσετε τα πράσινα μοσχεύματα (τριαντάφυλλα, ιπποφαές, λιλά, λουλούδια εσωτερικού χώρου), χρησιμοποιήστε μια ουσία σε εναιώρημα, η οποία προστίθεται στο νερό. Το διάλυμα αποθηκεύεται σε θερμοκρασία +5 °C, όχι περισσότερο από ένα μήνα. Αφήστε το να ζεσταθεί πριν από τη χρήση.
Πλεονεκτήματα και μειονεκτήματα
Το μυκητοκτόνο "Glyocladin" (βλ. Φωτογραφία) έχει πολλά πλεονεκτήματα, όπως:
- Εύχρηστος.
- Εφάπαξ επεξεργασία.
- Ασφάλεια για ανθρώπους, ζώα, ψάρια και πουλιά.
- Μη τοξικό.
- Αποτελεσματικότητα στην καταπολέμηση παθογόνων παραγόντων πολλών ασθενειών.
- Μακροπρόθεσμη ισχύς.
- Η ικανότητα αύξησης της απόδοσης.
- Βελτίωση του εδάφους και βελτίωση της μικροχλωρίδας του.
- Εξαλείψτε την ανάγκη για χημικά φυτοφάρμακα.
- Δράση που τονώνει την ανάπτυξη.
Από τα μειονεκτήματα του φαρμάκου, μπορεί να σημειωθεί μόνο το γεγονός ότι συχνά παραποιείται. Αγοράζοντας ένα προϊόν χαμηλής ποιότητας, υπάρχει πιθανότητα να βλάψετε τον κήπο ή να μην δείτε το αποτέλεσμα.

Όταν αγοράζετε ένα φάρμακο, είναι σημαντικό να προσέχετε τα πλαστά.
Συμβατότητα με άλλα φάρμακα
Η «γλυκολαδίνη» μπορεί να συνδυαστεί με άλλα βιομυκητοκτόνα, εντομοκτόνα, λιπάσματα, ρυθμιστές ανάπτυξης και χημικά ζιζανιοκτόνα. Για να αυξήσει την αποτελεσματικότητα, μπορεί να χρησιμοποιηθεί σε συνδυασμό με το φάρμακο "Planriz", "Gamair", "Alirin".
Ένας περιορισμός είναι η ταυτόχρονη χρήση με χημικά μυκητοκτόνα, καθώς και με άλλα φυτοφάρμακα, με εξαίρεση τα ανάλογα που περιέχουν στελέχη Trichoderma.
Μέτρα ασφαλείας
Τα δισκία για φυτά "Γλυκολαδίνη" έχουν τάξη κινδύνου 4, αβλαβή για την ανθρώπινη υγεία και πρακτικά μη τοξικά για τα φυτά, μπορούν να χρησιμοποιηθούν στην περιοχή των υδάτινων σωμάτων.
Εάν ένα άτομο καταπιεί κατά λάθος ένα χάπι του φαρμάκου, για να αποτρέψει δυσάρεστες συνέπειες, είναι απαραίτητο να πλύνετε το στομάχι και να συμβουλευτείτε έναν γιατρό. Είναι καλύτερα να δουλεύετε με την ουσία με γάντια.

Η περίοδος ισχύος του "Glyokladin" είναι 2 μήνες μετά την παραγωγή
Κανόνες αποθήκευσης
Το Biocomplex "Glyokladin" πρέπει να φυλάσσεται σε δροσερό ξηρό δωμάτιο, σε θερμοκρασία + 6-14 °C, μακριά από τα ναρκωτικά και τα τρόφιμα. Το μέρος πρέπει να είναι μακριά από παιδιά και ζώα.
Σε σφραγισμένη συσκευασία, το "Glyokladin" αποθηκεύεται για δύο χρόνια.
Τα ανάλογα του Γλυκοκλαδίνου
Το εργαλείο μπορεί να αντικατασταθεί με φάρμακα παρόμοια στον μηχανισμό δράσης, είναι:
- Τριχοκίνη.
- Τριχοδερμίνη.
- Τριζοζάν.
- Trichoflor.
- Αλιρίν-Β.
- Gamair.
- Μπακτόφιτ.
Πριν χρησιμοποιήσετε κάθε φάρμακο, είναι σημαντικό να διαβάσετε προσεκτικά τις οδηγίες. Βεβαιωθείτε ότι μετά την εφαρμογή τους, το επιθυμητό αποτέλεσμα και όφελος θα επιτευχθούν πλήρως.

Για την πρόληψη της σήψης των ριζών, χρησιμοποιήστε 1 δισκίο σε βάθος τουλάχιστον 1 cm
συμπέρασμα
Οι οδηγίες για τη χρήση της Γλυοκλαδίνης για τα φυτά ενημερώνουν ότι ο παράγοντας είναι σε θέση να αποτρέψει ασθένειες των οικιακών και των φυτών κήπου χωρίς να έχει επιζήμια επίδραση σε αυτά. Κρίνοντας από τις πολλές κριτικές για το φάρμακο, οι κηπουροί ήταν πεπεισμένοι για την αποτελεσματικότητά του από τη δική τους εμπειρία και κάθε χρόνο προσπαθούν να χρησιμοποιούν ένα βιολογικό μυκητοκτόνο στις δικές τους αυλές. Η δημοτικότητα των χαπιών αυξάνεται από χρόνο σε χρόνο.